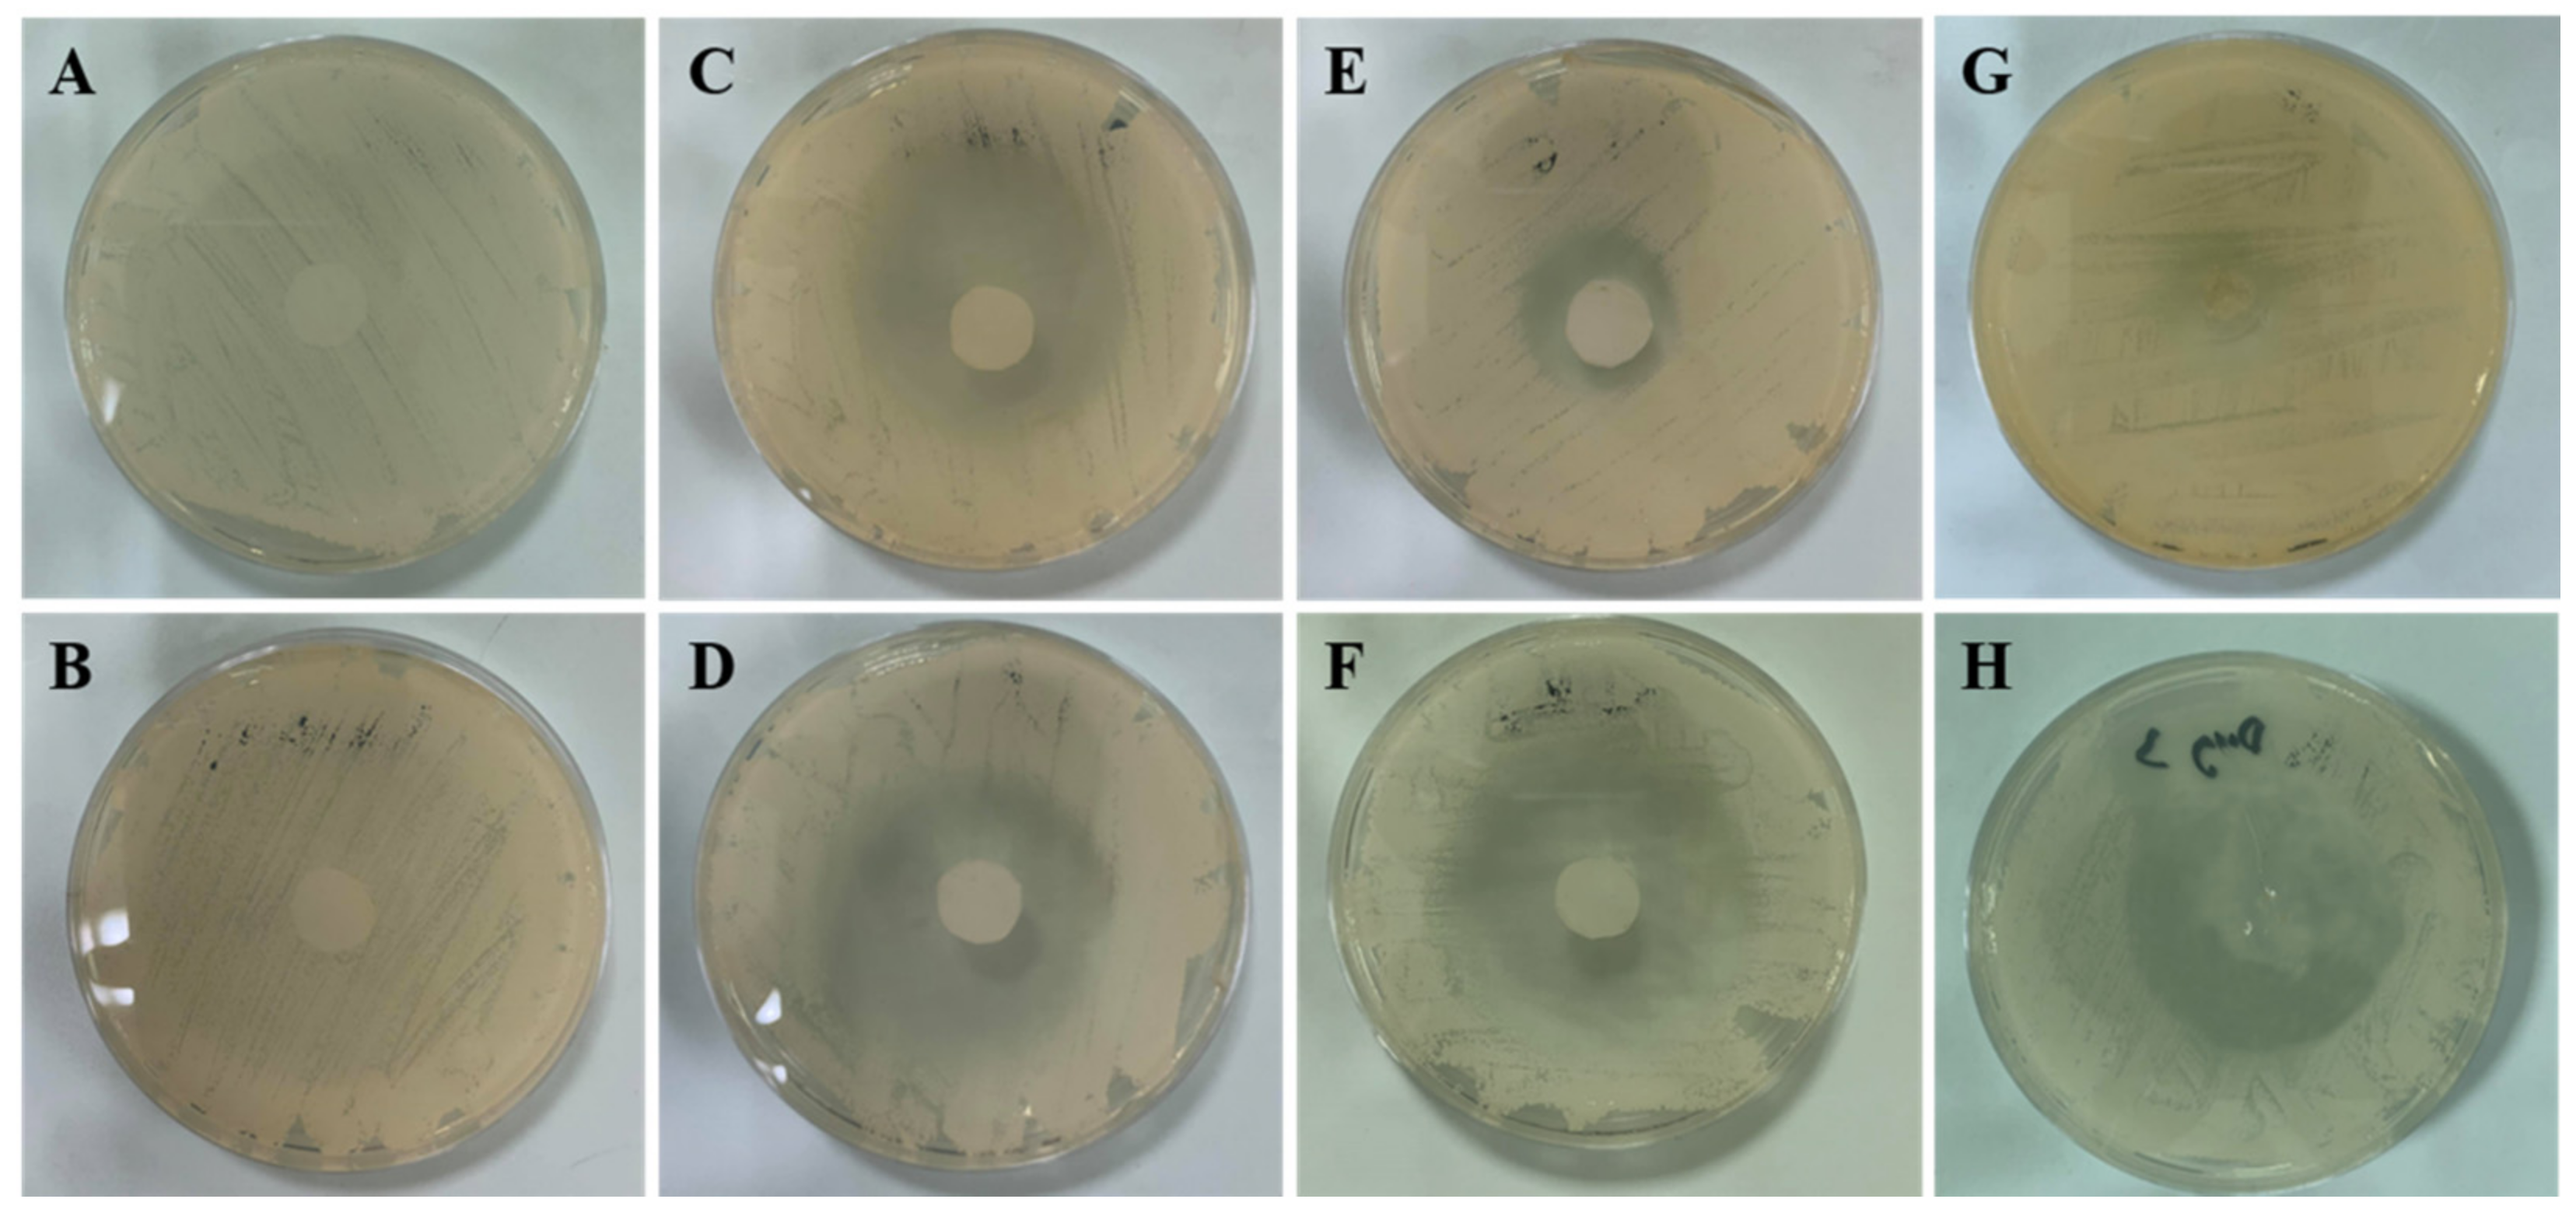
Pharmaceutics 14 00472 g010 Pharmaceutics 14 00472 g010

Optimal Design of Novel Microemulsions-Based Two-Layered Dissolving Microneedles for Delivering Fluconazole in Treatment of Fungal Eye Infection
Abstract
1. Introduction
2. Materials and Methods
2.1. Materials
2.2. Construction of Pseudo-Ternary Phase Diagrams
2.3. Formulation of FLUZ Loaded MEs
2.4. Development and Optimization of FLUZ Loaded MEs Using I-Optimal Design
2.5. Characterization of FLUZ-Loaded MEs
2.5.1. Droplet Size, PDI, and Zeta Potential Measurement
2.5.2. pH Value
2.5.3. Centrifugation Test
2.5.4. Drug Content Determination
2.5.5. Percent of Permeation at 8 h
2.6. Fabrication of FLUZ-MEs-Loaded Two-Layered Dissolving MNs
2.7. The Physical Appearance of MEs-Loaded Two-Layered Dissolving MNs and FLUZ Content
2.8. Preparation of Porcine Eyeballs and Corneal Tissue
2.9. Mechanical Strength and Insertion Force of FLUZ-MEs-Loaded Two-Layered Dissolving MNs
2.10. Determination of Complete Insertion and Depth of Insertion
2.11. Dissolution Times of FLUZ-MEs-Loaded Two-Layered Dissolving MNs
2.12. In Vitro Ocular Permeation of FLUZ-MEs-Loaded Two-Layered Dissolving MNs
2.13. The %FLUZ Retained in Corneal Tissues
2.14. Ex Vivo Ocular Drug Delivery of FLUZ-MEs-Loaded Two-Layered Dissolving MNs
2.15. Antifungal Activity of FLUZ-MEs-Loaded Two-Layered Dissolving MNs
2.16. Stability Study Test
2.17. Statistics Analysis
3. Results and Discussion
3.1. Construction of Pseudo-Ternary Phase Diagrams
3.2. Development and Optimization of FLUZ-Loaded MEs Using I-Optimal Design
3.3. The Physical Appearance of MEs-Loaded Two-Layered Dissolving MNs and FLUZ Content
3.4. Mechanical Strength and Insertion Force of FLUZ-MEs-Loaded Two-Layered Dissolving MNs
3.5. Determination of Complete Insertion and Depth of Insertion in Ocular Tissues
3.6. In Vitro Ocular Permeation of FLUZ-ME- Loaded Two-Layered Dissolving MNs and FLUZ Remaining in Corneal Tissue
3.7. Ex Vivo Ocular Drug Delivery of FLUZ-MEs-Loaded Two-Layered Dissolving MNs
3.8. Antifungal Activity of FLUZ-MEs-Loaded Two-Layered Dissolving MNs
3.9. Stability Test
4. Conclusions
Supplementary Materials
Author Contributions
Funding
Institutional Review Board Statement
Informed Consent Statement
Data Availability Statement
Acknowledgments
Conflicts of Interest
References
- Collier, S.A.; Gronostaj, M.P.; MacGurn, A.K.; Cope, J.R.; Awsumb, K.L.; Yoder, J.S.; Beach, M.J. Estimated burden of keratitis—United States, 2010. MMWR Morb. Mortal. Wkly. Rep. 2014, 63, 1027–1030. [Google Scholar] [PubMed]
- Thomas, P.A. Fungal infections of the cornea. Eye 2003, 17, 852–862. [Google Scholar] [CrossRef] [PubMed]
- Mannermaa, E.; Vellonen, K.S.; Urtti, A. Drug transport in corneal epithelium and blood-retina barrier: Emerging role of transporters in ocular pharmacokinetics. Adv. Drug Deliv. Rev. 2006, 58, 1136–1163. [Google Scholar] [CrossRef]
- Gaudana, R.; Jwala, J.; Boddu, S.H.; Mitra, A.K. Recent perspectives in ocular drug delivery. Pharm. Res. 2009, 26, 1197–1216. [Google Scholar] [CrossRef] [PubMed]
- Järvinen, K.; Järvinen, T.; Urtti, A. Ocular absorption following topical delivery. Adv. Drug Deliv. Rev. 1995, 16, 3–19. [Google Scholar] [CrossRef]
- Lang, J.C. Ocular drug delivery conventional ocular formulations. Adv. Drug Deliv. Rev. 1995, 16, 39–43. [Google Scholar] [CrossRef]
- Thakkar, R.; Patil, A.; Mehraj, T.; Dudhipala, N.; Majumdar, S. Updates in ocular antifungal pharmacotherapy: Formulation and clinical perspectives. Curr. Fungal Infect. Rep. 2019, 13, 45–58. [Google Scholar] [CrossRef]
- Fetih, G. Fluconazole-loaded niosomal gels as a topical ocular drug delivery system for corneal fungal infections. J. Drug Deliv. Sci. Technol. 2016, 35, 8–15. [Google Scholar] [CrossRef]
- Moustafa, M.A.; Elnaggar, Y.S.R.; El-Refaie, W.M.; Abdallah, O.Y. Hyalugel-integrated liposomes as a novel ocular nanosized delivery system of fluconazole with promising prolonged effect. Int. J. Pharm. 2017, 534, 14–24. [Google Scholar] [CrossRef]
- Pathak, M.K.; Chhabra, G.; Pathak, K. Design and development of a novel pH triggered nanoemulsified in-situ ophthalmic gel of fluconazole: Ex-vivo transcorneal permeation, corneal toxicity and irritation testing. Drug Dev. Ind. Pharm. 2013, 39, 780–790. [Google Scholar] [CrossRef]
- Mahdy, R.A.; Nada, W.M.; Wageh, M.M. Topical amphotericin B and subconjunctival injection of fluconazole (combination therapy) versus topical amphotericin B (monotherapy) in treatment of keratomycosis. J. Ocul. Pharmacol. Ther. 2010, 26, 281–285. [Google Scholar] [CrossRef] [PubMed]
- You, X.; Li, J.; Li, S.; Shi, W. Effects of lamellar keratectomy and intrastromal injection of 0.2% fluconazole on fungal keratitis. J. Ophthalmol. 2015, 2015, 656027. [Google Scholar] [CrossRef] [PubMed]
- ElMeshad, A.N.; Mohsen, A.M. Enhanced corneal permeation and antimycotic activity of itraconazole against Candida albicans via a novel nanosystem vesicle. Drug Deliv. 2016, 23, 2115–2123. [Google Scholar] [CrossRef]
- Soliman, O.A.E.; Mohamed, E.A.; Khatera, N.A.A. Enhanced ocular bioavailability of fluconazole from niosomal gels and microemulsions: Formulation, optimization, and in vitro-in vivo evaluation. Pharm. Dev. Technol. 2019, 24, 48–62. [Google Scholar] [CrossRef] [PubMed]
- Elkasabgy, N.A. Ocular supersaturated self-nanoemulsifying drug delivery systems (S-SNEDDS) to enhance econazole nitrate bioavailability. Int. J. Pharm. 2014, 460, 33–44. [Google Scholar] [CrossRef] [PubMed]
- Hegde, R.R.; Bhattacharya, S.S.; Verma, A.; Ghosh, A. Physicochemical and pharmacological investigation of water/oil microemulsion of non-selective beta blocker for treatment of glaucoma. Curr. Eye Res. 2014, 39, 155–163. [Google Scholar] [CrossRef] [PubMed]
- Kumar, R.; Sinha, V.R. Preparation and optimization of voriconazole microemulsion for ocular delivery. Colloids Surf. B Biointerfaces 2014, 117, 82–88. [Google Scholar] [CrossRef] [PubMed]
- Silva-Cunha, A.; da Silva, G.R.; de Castro, W.V.; Fialho, S.L. Evaluation of the pharmacokinetics and ocular tolerance of a microemulsion containing tacrolimus. J. Ocul. Pharmacol. Ther. 2014, 30, 59–65. [Google Scholar] [CrossRef]
- Tiwari, R.; Dubey, V.; Kesavan, K. Ocular Self-Microemulsifying Drug Delivery System of Prednisolone Improves Therapeutic Effectiveness in the Treatment of Experimental Uveitis. Ocul. Immunol. Inflamm. 2019, 27, 303–311. [Google Scholar] [CrossRef]
- Üstündag-Okur, N.; Gökçe, E.H.; Eğrilmez, S.; Özer, Ö.; Ertan, G. Novel ofloxacin-loaded microemulsion formulations for ocular delivery. J. Ocul. Pharmacol. Ther. 2014, 30, 319–332. [Google Scholar] [CrossRef]
- Suriyaamporn, P.; Opanasopit, P.; Ngawhirunpat, T.; Rangsimawong, W. Computer-aided rational design for optimally Gantrez® S-97 and hyaluronic acid-based dissolving microneedles as a potential ocular delivery system. J. Drug Deliv. Sci. Technol. 2021, 61, 102319. [Google Scholar] [CrossRef]
- Roy, G.; Galigama, R.D.; Thorat, V.S.; Mallela, L.S.; Roy, S.; Garg, P.; Venuganti, V.V.K. Amphotericin B containing microneedle ocular patch for effective treatment of fungal keratitis. Int. J. Pharm. 2019, 572, 118808. [Google Scholar] [CrossRef]
- Ramalheiro, A.; Paris, J.L.; Silva, B.F.B.; Pires, L.R. Rapidly dissolving microneedles for the delivery of cubosome-like liquid crystalline nanoparticles with sustained release of rapamycin. Int. J. Pharm. 2020, 591, 119942. [Google Scholar] [CrossRef] [PubMed]
- Abdelghany, S.; Tekko, I.A.; Vora, L.; Larraneta, E.; Permana, A.D.; Donnelly, R.F. Nanosuspension-based dissolving microneedle arrays for intradermal delivery of curcumin. Pharmaceutics 2019, 11, 308. [Google Scholar] [CrossRef] [PubMed]
- Permana, A.D.; Paredes, A.J.; Volpe-Zanutto, F.; Anjani, Q.K.; Utomo, E.; Donnelly, R.F. Dissolving microneedle-mediated dermal delivery of itraconazole nanocrystals for improved treatment of cutaneous candidiasis. Eur. J. Pharm. Biopharm. 2020, 154, 50–61. [Google Scholar] [CrossRef] [PubMed]
- Ganggwar, N.; Singh, M.; Parashar, P.; Tripathi, C.B.; Arya, M.; Saraf, S.; Saha, S. Topical delivery of fluconazole via microemulsion incorporated hydrogel for the management of fungal dermatophytosis. Curr. Drug Ther. 2016, 11, 129–141. [Google Scholar] [CrossRef]
- Jaya, K.; Raja Kumar, J.; Muralidharan, S.; Sokkalingam, A.; So, D. Anti-fungal activity of microemulsion based fluconazole gel for onychomycosis against aspergillus niger. Int. J. Pharm. Pharm. Sci. 2012, 5, 96–102. [Google Scholar]
- Patel, R.J.; Patel, M.M. Linagliptin loaded solid-SMEEDS for enhanced solubility and dissolution: Formulation development and optimization by D-optimal design. J. Drug Deliv. Ther. 2019, 9, 47–56. [Google Scholar] [CrossRef]
- Anwar, F.; Jahangir, M. Preparation and evaluation of antifungal micro-emulsion/gel using reduce dose of silver, supported by ciprofloxacin introduction. Int. Pharm. Sci. 2012, 2, 72–87. [Google Scholar]
- Rao, S.; Barot, T.; Rajesh, K.S.; Jha, L.L. Formulation, optimization and evaluation of microemulsion based gel of Butenafine Hydrochloride for topical delivery by using simplex lattice mixture design. J. Pharm. Investig. 2015, 46, 1–12. [Google Scholar] [CrossRef]
- Hurtado, F.; Souza, M.; Melo, J.; Rolim, C. Microbiological assay and HPLC method for the determination of fluconazole in pharmaceutical injectable formulations. Lat. Am. J. Pharm. 2008, 27, 224–228. [Google Scholar]
- Dathathri, E.; Lal, S.; Mittal, M.; Thakur, G.; De, S. Fabrication of low-cost composite polymer-based micro needle patch for transdermal drug delivery. Appl. Nanosci. 2019, 10, 371–377. [Google Scholar] [CrossRef]
- Aung, N.N.; Ngawhirunpat, T.; Rojanarata, T.; Patrojanasophon, P.; Pamornpathomkul, B.; Opanasopit, P. Fabrication, characterization and comparison of α-arbutin loaded dissolving and hydrogel forming microneedles. Int. J. Pharm. 2020, 586, 119508. [Google Scholar] [CrossRef] [PubMed]
- Sanchez, I.; Martin, R.; Ussa, F.; Fernandez-Bueno, I. The parameters of the porcine eyeball. Graefes Arch. Clin. Exp. Ophthalmol. 2011, 249, 475–482. [Google Scholar] [CrossRef] [PubMed]
- Nicoli, S.; Ferrari, G.; Quarta, M.; Macaluso, C.; Govoni, P.; Dallatana, D.; Santi, P. Porcine sclera as a model of human sclera for in vitro transport experiments: Histology, SEM, and comparative permeability. Mol. Vis. 2009, 15, 259–266. [Google Scholar] [PubMed]
- Thakur, R.R.; Tekko, I.A.; Al-Shammari, F.; Ali, A.A.; McCarthy, H.; Donnelly, R.F. Rapidly dissolving polymeric microneedles for minimally invasive intraocular drug delivery. Drug Deliv. Transl. Res. 2016, 6, 800–815. [Google Scholar] [CrossRef] [PubMed]
- Albadr, A.A.; Tekko, I.A.; Vora, L.K.; Ali, A.A.; Laverty, G.; Donnelly, R.F.; Thakur, R.R.S. Rapidly dissolving microneedle patch of amphotericin B for intracorneal fungal infections. Drug Deliv. Transl. Res. 2021, 1–13. [Google Scholar] [CrossRef] [PubMed]
- Than, A.; Liu, C.; Chang, H.; Duong, P.K.; Cheung, C.M.G.; Xu, C.; Wang, X.; Chen, P. Self-implantable double-layered micro-drug-reservoirs for efficient and controlled ocular drug delivery. Nat. Commun. 2018, 9, 4433. [Google Scholar] [CrossRef]
- Jung, J.H.; Chiang, B.; Grossniklaus, H.E.; Prausnitz, M.R. Ocular drug delivery targeted by iontophoresis in the suprachoroidal space using a microneedle. J. Control. Release 2018, 277, 14–22. [Google Scholar] [CrossRef]
- Kim, Y.C.; Oh, K.H.; Edelhauser, H.F.; Prausnitz, M.R. Formulation to target delivery to the ciliary body and choroid via the suprachoroidal space of the eye using microneedles. Eur. J. Pharm. Biopharm. 2015, 95, 398–406. [Google Scholar] [CrossRef]
- Mitchell, B.M.; Wu, T.G.; Jackson, B.E.; Wilhelmus, K.R. Candida albicans strain-dependent virulence and Rim13p-mediated filamentation in experimental keratomycosis. Investig. Ophthalmol. Vis. Sci. 2007, 48, 774–780. [Google Scholar] [CrossRef] [PubMed]
- Hegde, R.R.; Verma, A.; Ghosh, A. Microemulsion: New insights into the ocular drug delivery. ISRN Pharm. 2013, 2013, 826798. [Google Scholar] [CrossRef] [PubMed]
- Danaei, M.; Dehghankhold, M.; Ataei, S.; Hasanzadeh Davarani, F.; Javanmard, R.; Dokhani, A.; Khorasani, S.; Mozafari, M.R. Impact of particle size and polydispersity index on the clinical applications of lipidic nanocarrier systems. Pharmaceutics 2018, 10, 57. [Google Scholar] [CrossRef] [PubMed]
- Thakur Singh, R.R.; Tekko, I.; McAvoy, K.; McMillan, H.; Jones, D.; Donnelly, R.F. Minimally invasive microneedles for ocular drug delivery. Expert Opin. Drug Deliv. 2017, 14, 525–537. [Google Scholar] [CrossRef]
- Masoumi, H.R.F.; Basri, M.; Samiun, W.S.; Izadiyan, Z.; Lim, C.J. Enhancement of encapsulation efficiency of nanoemulsion-containing aripiprazole for the treatment of schizophrenia using mixture experimental design. Int. J. Nanomed. 2015, 10, 6469–6476. [Google Scholar] [CrossRef]
- Lim, L.T.; Ah-Kee, E.Y.; Collins, C.E. Common eye drops and their implications for pH measurements in the management of chemical eye injuries. Int. J. Ophthalmol. 2014, 7, 1067–1068. [Google Scholar] [CrossRef]
- Inomata, T.; Mashaghi, A.; Hong, J.; Nakao, T.; Dana, R. Scaling and maintenance of corneal thickness during aging. PLoS ONE 2017, 12, e0185694. [Google Scholar] [CrossRef] [PubMed]
- Doughty, M.J.; Zaman, M.L. Human corneal thickness and its impact on intraocular pressure measures: A review and meta-analysis approach. Surv. Ophthalmol. 2000, 44, 367–408. [Google Scholar] [CrossRef]
- Dash, A.K.; Elmquist, W.F. Fluconazole. In Analytical Profiles of Drug Substances and Excipients; Brittain, H.G., Ed.; Academic Press: San Diego, CA, USA, 2001; Volume 27, pp. 67–113. [Google Scholar]
- Vandamme, T.F. Microemulsions as ocular drug delivery systems: Recent developments and future challenges. Prog. Retin. Eye Res. 2002, 21, 15–34. [Google Scholar] [CrossRef]
- Müller, G.G.; Kara-José, N.; Castro, R.S.D. Antifungals in eye infections: Drugs and routes of administration. Rev. Bras. Oftalmol. 2013, 72, 132–141. [Google Scholar] [CrossRef]
- Hassan, H.A.; Geniady, M.M.; Abdelwahab, S.F.; Abd-Elghany, M.I.; Sarhan, H.A.; Abdelghany, A.A.; Kamel, M.S.; Rodriguez, A.E.; Alio, J.L. Topical eugenol successfully treats experimental Candida albicans-induced keratitis. Ophthalmic Res. 2018, 60, 69–79. [Google Scholar] [CrossRef] [PubMed]

| Batches | Input Factor1 A: Oil (% w/w) | Input Factor2 B: Smix (% w/w) | Input Factor3 C: Water (% w/w) | Output Factor1 Size (nm) | Output Factor2 PDI | Output Factor3 Drug Content (mg/mL) | Output Factor4 %Permeation at 8 h (%) |
|---|---|---|---|---|---|---|---|
| 1 | 16.89 | 66.25 | 16.86 | 635.03 | 0.42 | 41.82 | 1.86 |
| 2 | 15.33 | 77.60 | 7.06 | 603.20 | 0.61 | 64.08 | 1.37 |
| 3 | 6.63 | 68.38 | 25.00 | 625.80 | 0.62 | 31.67 | 0.63 |
| 4 | 7.04 | 77.39 | 15.57 | 668.00 | 0.65 | 28.43 | 0.66 |
| 5 | 25.00 | 68.33 | 6.67 | 970.83 | 0.95 | 90.28 | 1.36 |
| 6 | 21.61 | 66.25 | 12.14 | 179.13 | 0.30 | 87.92 | 1.64 |
| 7 | 16.89 | 66.25 | 16.86 | 634.37 | 0.60 | 71.31 | 2.08 |
| 8 | 15.33 | 77.60 | 7.06 | 725.70 | 0.58 | 63.08 | 1.09 |
| 9 | 7.04 | 77.39 | 15.57 | 522.10 | 0.79 | 26.53 | 1.15 |
| 10 | 6.25 | 82.57 | 11.18 | 577.00 | 0.68 | 38.72 | 0.44 |
| 11 | 6.25 | 87.50 | 6.25 | 504.80 | 0.56 | 42.10 | 0.81 |
| 12 | 10.55 | 70.72 | 18.73 | 632.97 | 0.50 | 46.38 | 0.97 |
| 13 | 15.01 | 72.36 | 12.63 | 505.47 | 0.77 | 42.90 | 1.91 |
| 14 | 11.05 | 82.70 | 6.25 | 1322.67 | 0.72 | 58.55 | 1.28 |
| Factors | Criteria | Solutions | Desirability |
|---|---|---|---|
| A: Oil (% w/w) | is in range | 20.54% w/w | 0.83 |
| B: Smix (% w/w) | is in range | 67.70% w/w | |
| C: Water (% w/w) | is in range | 11.76% w/w | |
| Size (nm) | Minimize | 119.85 nm | |
| PDI | none | ||
| Drug content (mg/mL) | Maximize | 74.13 mg/mL | |
| % of permeation at 8 h (%) | Maximize | 1.78% |
| Results | Output Factors | ||
|---|---|---|---|
| Size (nm) | Drug Content (mg/mL) | % of Permeation at 8 h (%) | |
| Predicted value | 119.85 ± 0.00 | 74.13 ± 0.00 | 1.78 ± 0.00 |
| Actual value | 121.22 ± 9.01 | 73.58 ± 0.54 | 1.57 ± 0.22 |
| t-test (p-value) | 0.81 | 0.15 | 0.17 |
| Ocular Permeation Profile # | Formulations | ||||
|---|---|---|---|---|---|
| FLUZ Suspension | FLUZ in Eugenol | FLUZ Loaded Optimal MEs | FLUZ-Suspension-Loaded MNs | FLUZ-MEs-Loaded Two-Layered MNs | |
| Lag time (h) | 0.00 ± 0.00 | 0.60 ± 0.12 | 0.74 ± 0.30 | 0.18 ± 0.06 | 0.19 ± 0.08 |
| J (mg/cm2/h) | 0.00 ± 0.00 | 0.12 ± 0.01 | 0.39 ± 0.03 | 0.11 ± 0.02 | 0.70 ± 0.13 * |
| Q24/A (mg/cm2) | 0.00 ± 0.00 | 1.26 ± 0.05 | 4.72 ± 0.84 | 0.64 ± 0.04 | 9.19 ± 0.33 * |
| Kd (×10−3, cm2/h) | 0.00 ± 0.00 | 1.02 ± 0.21 | 0.89 ± 0.31 | 3.66 ± 1.47 | 3.56 ± 1.20 |
| Kp (×10−3, cm2/h) | 0.00 ± 0.00 | 9.17 ± 0.70 | 30.93 ± 2.06 | 8.60 ± 1.52 | 55.17 ± 10.36 * |
| % FLUZ retained in cornea (%) | 0.00 ± 0.00 | 27.72 ± 4.33 | 14.94 ± 1.34 | 16.90 ± 3.28 | 38.45 ± 3.27 * |
| Formulations # | A | B | C | D | E | F | G | H |
|---|---|---|---|---|---|---|---|---|
| % of zone inhibition (%) | 0.00 ±0.00 | 0.00 ±0.00 | 50.39 ±3.02 | 58.82 ±5.88 | 36.08 ±1.36 | 60.00 ±2.04 | 3.92 ±1.70 | 61.96 ±5.80 |
Publisher’s Note: MDPI stays neutral with regard to jurisdictional claims in published maps and institutional affiliations. |
© 2022 by the authors. Licensee MDPI, Basel, Switzerland. This article is an open access article distributed under the terms and conditions of the Creative Commons Attribution (CC BY) license (https://creativecommons.org/licenses/by/4.0/).
Share and Cite
Suriyaamporn, P.; Opanasopit, P.; Rangsimawong, W.; Ngawhirunpat, T. Optimal Design of Novel Microemulsions-Based Two-Layered Dissolving Microneedles for Delivering Fluconazole in Treatment of Fungal Eye Infection. Pharmaceutics 2022, 14, 472. https://doi.org/10.3390/pharmaceutics14030472
Suriyaamporn P, Opanasopit P, Rangsimawong W, Ngawhirunpat T. Optimal Design of Novel Microemulsions-Based Two-Layered Dissolving Microneedles for Delivering Fluconazole in Treatment of Fungal Eye Infection. Pharmaceutics. 2022; 14(3):472. https://doi.org/10.3390/pharmaceutics14030472
Chicago/Turabian StyleSuriyaamporn, Phuvamin, Praneet Opanasopit, Worranan Rangsimawong, and Tanasait Ngawhirunpat. 2022. "Optimal Design of Novel Microemulsions-Based Two-Layered Dissolving Microneedles for Delivering Fluconazole in Treatment of Fungal Eye Infection" Pharmaceutics 14, no. 3: 472. https://doi.org/10.3390/pharmaceutics14030472
APA StyleSuriyaamporn, P., Opanasopit, P., Rangsimawong, W., & Ngawhirunpat, T. (2022). Optimal Design of Novel Microemulsions-Based Two-Layered Dissolving Microneedles for Delivering Fluconazole in Treatment of Fungal Eye Infection. Pharmaceutics, 14(3), 472. https://doi.org/10.3390/pharmaceutics14030472







